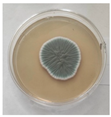
Fermentation 10 00058 i010
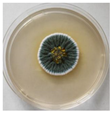
Fermentation 10 00058 i011

A Novel Extracellular Catalase Produced by the Antarctic Filamentous Fungus Penicillium Rubens III11-2
Abstract
1. Introduction
2. Materials and Methods
2.1. Microorganisms and Identification
Molecular Methods for Identification of Isolates
2.2. Screening for Catalase Activity
2.2.1. Cultivation on Solid Media
2.2.2. Submerged Cultivation
2.3. Analytical Methods—Determination of Enzyme Activities, Sugars, Protein, Dry Weight
2.4. Isolation and Purification of Temperature-Sensitive Catalase
2.5. Determination of Temperature Optimum and Temperature Stability of the Purified Enzyme
2.5.1. Determination of Temperature Optimum
2.5.2. Determination of Temperature Stability
2.6. Statistical Evaluation of the Results
3. Results
3.1. Investigation on the Potential of Antarctic Filamentous Fungi for the Catalase Synthesis
3.2. Identification of Extracellular Catalase-Producing Strains
3.3. Selection of an Extracellular Catalase-Producing Strain
3.4. Investigation of the Role of Extracellular Catalase under Normoxic Conditions and under Low-Temperature Stress
3.5. Purification and Characterization of CA CAT
3.5.1. Preparation of Purified Enzyme
3.5.2. Properties of the Purified Enzyme Preparation
4. Discussion
5. Conclusions
Author Contributions
Funding
Data Availability Statement
Conflicts of Interest
References
- Onofri, S.; Selbmann, L.; de Hoog, G.S.; Grube, M.; Barreca, D.; Ruisi, S.; Zucconi, L. Evolution and adaptation of fungi at boundaries of life. Adv. Space Res. 2007, 40, 1657–1664. [Google Scholar] [CrossRef]
- Dasila, H.; Maithani, D.; Suyal, D.C.; Debbarma, P. Cold-Adapted Microorganisms: Survival Strategies and Biotechnological Significance. In Survival Strategies in Cold-Adapted Microorganisms; Goel, R., Soni, R., Suyal, D.C., Khan, M., Eds.; Springer: Singapore, 2022; pp. 357–378. [Google Scholar]
- Shen, L.; Zhang, S.; Chen, G. Regulated strategies of cold-adapted microorganisms in response to cold: A review. Environ. Sci. Polluti. R. 2021, 28, 68006–68024. [Google Scholar] [CrossRef] [PubMed]
- Feller, G.; Gerday, C. Psychrophilic enzymes: Hot topics in cold adaptation. Nat. Rev. Microbiol. 2003, 1, 200–208. [Google Scholar] [CrossRef]
- Gatti-Lafranconi, P.; Natalello, A.; Rehm, S.; Doglia, S.M.; Pleiss, J.; Lotti, M. Evolution of stability in a cold-active enzyme elicits specificity relaxation and highlights substrate-related effects on temperature adaptation. J. Mol. Biol. 2010, 395, 155–166. [Google Scholar] [CrossRef]
- Liu, Y.; Zhang, N.; Ma, J.; Zhou, Y.; Wei, Q.; Tian, C.; Fang, Y.; Zhong, R.; Chen, G.; Zhang, S. Advances in cold-adapted enzymes derived from microorganisms. Front. Microbiol. 2023, 14, 1152847. [Google Scholar] [CrossRef] [PubMed]
- Russell, N.J. Membrane components and cold sensing. In Psychrophiles: From Biodiversity to Biotechnology; Springer: Berlin/Heidelberg, Germany, 2008; pp. 177–190. [Google Scholar]
- Kwak, K.J.; Park, S.J.; Han, J.H.; Kim, M.K.; Oh, S.H.; Han, Y.S.; Kang, H. Structural determinants crucial to the RNA chaperone activity of glycine-rich RNA-binding proteins 4 and 7 in Arabidopsis thaliana during the cold adaptation process. J. Exp. Bot. 2011, 62, 4003–4011. [Google Scholar] [CrossRef] [PubMed]
- García-Arribas, O.; Mateo, R.; Tomczak, M.M.; Davies, P.L.; Mateu, M.G. Thermodynamic stability of a cold-adapted protein, type III antifreeze protein, and energetic contribution of salt bridges. Protein Sci. 2007, 16, 227–238. [Google Scholar] [CrossRef] [PubMed]
- Chattopadhyay, M.K. Low temperature and oxidative stress. Curr. Sci. 2002, 83, 109. [Google Scholar]
- Gocheva, Y.; Tosi, S.; Krumova, E.; Slokoska, L.; Miteva, J.; Vassilev, S.; Angelova, M. Temperature downshift induces antioxidant response in fungi isolated from Antarctica. Extremophiles 2009, 13, 273–281. [Google Scholar] [CrossRef]
- Chattopadhyay, M.K.; Raghu, G.; Sharma, Y.V.R.K.; Biju, A.R.; Rajasekharan, M.V.; Shivaji, S. Increase in oxidative stress at low temperature in an Antarctic bacterium. Curr. Microbiol. 2011, 62, 544–546. [Google Scholar] [CrossRef]
- Kostadinova, N.; Krumova, E.; Stefanova, T.; Dishliyska, V.; Angelova, M. Transient cold shock induces oxidative stress events in Antarctic fungi. In Oxidative Stress. Book 1; Books on Demand GmbH: Norderstedt, Germany, 2012; pp. 75–99. [Google Scholar]
- Kawasaki, L.; Aguirre, J. Multiple catalase genes are differentially regulated in Aspergillus nidulans. J. Bacteriol. 2001, 183, 1434–1440. [Google Scholar] [CrossRef]
- Kacem-Chaouche, N.; Maraihi, Z.; Destain, J.; Thonart, P. Study of catalase production by an Aspergillus phoenicis mutant strain in date flour extract submerged cultures. Biotechnol. Agron. Soc. Environ. 2005, 9, 173–178. [Google Scholar]
- Hussein, F.; Hamed, R.R.; El-Beih, F.; Mostafa, E.M.; El-Shershaby, A. Enhanced production of catalase by Penicillium chrysogenum in benchtop bioreactor. Int. J. Sci. Eng. Res. 2015, 6, 735–739. [Google Scholar]
- Pongpom, P.; Cooper, C.R.; Vanittanakom, N. Isolation and characterization of a catalase-peroxidase gene from the pathogenic fungus, Penicillium marneffei. Med. Mycol. 2005, 43, 403–411. [Google Scholar] [CrossRef]
- Caridis, K.; Christakopoulos, P.; Macris, B.J. Simultaneous production of glucose oxidase and catalase by Alternaria alternate. Appl. Microbiol. Biotechnol. 1991, 34, 794–797. [Google Scholar] [CrossRef]
- Vatsyayan, P.; Goswami, P. Highly Active and Stable Large Catalase Isolated from a Hydrocarbon Degrading Aspergillus terreus MTCC 6324. Enzym. Res. 2016, 20, 4379403. [Google Scholar]
- Santoso, P.; Suryani, L.A.; Yopi, Y. Purification and Characterization of Catalase from Indigenous Fungi of Neurospora crassa InaCC F226. Int. J. Adv. Sci. Eng. Inf. Technol. 2016, 6, 502–507. [Google Scholar] [CrossRef]
- Susmitha, S.; Ranganayaki, P.; Vidyamol, K.K.; Vijayaraghavan, R. Purification and characterization of catalase enzyme from Agaricus bisporus. Int. J. Curr. Microbiol. Appl. Sci. 2013, 2, 255–263. [Google Scholar]
- Mina, S.; Marot-Leblond, A.; Cimon, B.; Fleury, M.J.; Larcher, G.; Bouchara, J.P.; Robert, R. Purification and characterization of a mycelial catalase from Scedosporium boydii, a useful tool for specific antibody detection in patients with cystic fibrosis. Clin. Vaccine Immunol. 2015, 22, 37–45. [Google Scholar] [CrossRef]
- Marqués-Gálvez, J.E.; Morte, A.; Navarro-Ródenas, A.; García-Carmona, F.; Pérez-Gilabert, M. Purification and characterization of Terfezia claveryi TcCAT-1, a desert truffle catalase upregulated in mycorrhizal symbiosis. PLoS ONE 2019, 14, e0219300. [Google Scholar] [CrossRef]
- Fiedurek, J.; Gromada, A. Production of catalase and glucose oxidase by Aspergillus niger using unconventional oxygenation of culture. J. Appl. Microbiol. 2000, 89, 85–89. [Google Scholar] [CrossRef]
- Abrashev, R.; Feller, G.; Kostadinova, N.; Krumova, E.; Alexieva, Z.; Gerginova, M.; Spasova, B.; Miteva-Staleva, J.; Vassilev, S.; Angelova, M. Production, purification, and characterization of a novel cold-active superoxide dismutase from the Antarctic strain Aspergillus glaucus 363. Fungal Biol. 2016, 120, 679–689. [Google Scholar] [CrossRef] [PubMed]
- Tosi, S.; Kostadinova, N.; Krumova, E.; Pashova, S.; Dishliiska, V.; Spassova, B.; Vassilev, S.; Angelova, M. Antioxidant enzyme activity of filamentous fungi isolated from Livingston Island. Maritime Antarctica. Polar Biol. 2010, 33, 1227–1237. [Google Scholar] [CrossRef]
- Feller, G. Molecular adaptations to cold in psychrophilic enzymes. Cell. Mol. Life Sci. 2003, 60, 648–662. [Google Scholar] [CrossRef] [PubMed]
- Yumoto, I.; Ichihashi, D.; Iwata, H.; Istokovics, A.; Ichise, N.; Matsuyama, H.; Okuyama, H.; Kawasaki, K. Purification and characterization of a catalase from the facultatively psychrophilic bacterium Vibrio rumoiensis S-1 exhibiting high catalase activity. J. Bacteriol. 2000, 182, 1903–1909. [Google Scholar] [CrossRef]
- Lorentzen, M.S.; Moe, E.; Jouve, H.M.; Willassen, N.P. Cold adapted features of Vibrio salmonicida catalase: Characterization and comparison to the mesophilic counterpart from Proteus mirabilis. Extrem. Life Extrem. Cond. 2006, 10, 427–440. [Google Scholar] [CrossRef]
- Zeng, H.W.; Cai, Y.J.; Liao, X.R.; Qian, S.L.; Zhang, F.; Zhang, D.B. Optimization of catalase production and purification and characterization of a novel cold-adapted Cat-2 from mesophilic bacterium Serratia marcescens SYBC-01. Ann. Microbiol. 2010, 60, 701–708. [Google Scholar] [CrossRef]
- Wang, W.; Sun, M.; Liu, W.; Zhang, B. Purification and characterization of a psychrophilic catalase from Antarctic Bacillus. Can. J. Microbiol. 2008, 54, 823–828. [Google Scholar] [CrossRef]
- Riise, E.K.; Lorentzen, M.S.; Helland, R.; Smalås, A.O.; Leiros, H.K.; Willassen, N.P. The first structure of a cold-active catalase from Vibrio salmonicida at 1.96 Å reveals structural aspects of cold adaptation. Acta Crystallogr. D Biol. Crystallogr. 2007, 63, 135–148. [Google Scholar] [CrossRef]
- Krumova, E.; Abrashev, R.; Dishliyska, V.; Stoyancheva, G.; Kostadinova, N.; Miteva-Staleva, J.; Spasova, B.; Angelova, M. Cold-active catalase from the psychrotolerant fungus Penicillium griseofulvum. J. Basic Microbiol. 2021, 61, 782–794. [Google Scholar] [CrossRef]
- Gromada, A.; Fiedurek, J. Selective isolation of Aspergillus niger mutants with enhanced glucose oxidase production. J. Appl. Microbiol. 1997, 82, 648–652. [Google Scholar] [CrossRef] [PubMed]
- Fiedurek, J.; Gromada, A. Screening and mutagenesis of molds for improvement of the simultaneous production of catalase and glucose oxidase. Enzym. Microb. Technol. 1997, 20, 344–347. [Google Scholar] [CrossRef]
- Isobe, K.; Inoue, N.; Takamatsu, Y.; Kamada, K.; Wakao, N. Production of catalase by fungi growing at low pH and high temperature. J. Biosci. Bioeng. 2006, 101, 73–76. [Google Scholar] [CrossRef] [PubMed]
- Fiedurek, J.; Gromada, A.; Słomka, A.; Korniłowicz-Kowalska, T.; Kurek, E.; Melke, J. Catalase activity in arctic microfungi grown at different temperatures. Acta Biol. Hung. 2003, 54, 105–112. [Google Scholar] [CrossRef] [PubMed]
- White, T.J.; Bruns, T.; Lee, S.; Taylor, J.W. PCR Protocols:A Guide to Methods and Applications; Innis, M.A., Gelfand, D.H., Sninsky, J.J., White, T.J., Eds.; Academi Press, Inc.: New York, NY, USA, 1990; pp. 315–322. [Google Scholar]
- Beauchamp, C.; Fridovich, I. Superoxide dismutase: Improved assays and an assay applicable to acrylamide gels. Anal. Biochem. 1971, 44, 276–287. [Google Scholar] [CrossRef] [PubMed]
- Beers, R.F.; Sizer, I.W. A spectrophotometric method for measuring the breakdown of hydrogen peroxide by catalase. J. Biol. Chem. 1952, 195, 133–140. [Google Scholar] [CrossRef]
- Somogyi, M. Notes on sugar determination. J. Biol. Chem. 1952, 195, 19–23. [Google Scholar] [CrossRef]
- Lowry, O.; Rosebrough, N.; Farr, A.L.; Randall, R. Protein measurement with the Folin phenol reagent. J. Biol. Chem. 1951, 193, 265–275. [Google Scholar] [CrossRef]
- Laemmli, U.K. Cleavage of structural proteins during the assembly of the head of bacteriophage T4. Nature 1970, 227, 680–685. [Google Scholar] [CrossRef]
- Woodbury, W.; Spencer, A.K.; Stahmann, M.A. An improved procedure using ferricyanide for detecting catalase isozymes. Anal. Biochem. 1971, 44, 301–305. [Google Scholar] [CrossRef]
- Zucconi, L.; Canini, F.; Temporiti, M.E.; Tosi, S. Extracellular enzymes and bioactive compounds from Antarctic terrestrial fungi for bioprospecting. Int. J. Environ. Res. Public Health 2020, 17, 6459. [Google Scholar] [CrossRef] [PubMed]
- Garre, V.; Tenberge, K.B.; Eising, R. Secretion of a fungal extracellular catalase by Claviceps purpurea during infection of rye: Putative role in pathogenicity and suppression of host defense. Phytopathology 1998, 88, 744–753. [Google Scholar] [CrossRef] [PubMed]
- Kacem Chaouche, N.; Destain, J.; Meraihi, Z.; Dehimat, L.; Haddoum, T.; Wathelet, J.P.; Thonart, P. Optimization of extracellular catalase production from Aspergillus phoenicis K30 by a linear regression method using date flour as single carbon source and purification of the enzyme. Afr. J. Biotechnol. 2013, 12, 2646–2653. [Google Scholar]
- Kurakov, A.V.; Kupletskaya, M.B.; Skrynnikova, E.V.; Somova, N.G. Search for micromycetes producing extracellular catalase and study of conditions of catalase synthesis. Appl. Biochem. Microbiol. 2001, 37, 59–64. [Google Scholar] [CrossRef]
- Agger, T.; Spohr, B.; Carlsen, M.; Nielsen, J. Growth and Product Formation zoom zoom zoom A B C Fig. 5. Solutions of Cases A-C 1 2 3 of Aspergillus oryzae during Submerged Cultivations: Verification of a Morphologically Structured Model Using Fluorescent Probes. Biotechnol. Bioeng. 1998, 57, 321–329. [Google Scholar] [CrossRef]
- Fenice, M.; Selbmann, L.; Zucconi, L.; Onofri, S. Production of extracellular enzymes by Antarctic fungal strains. Polar Biol. 1997, 17, 275–280. [Google Scholar] [CrossRef]
- Krumova, E.; Kostadinova, N.; Abrashev, R.; Miteva-Staleva, J.; Stoyancheva, G.; Dishlijska, V.; Spassova, B.; Angelova, M. Selection of catalase producers among Antarctic fungi. CR Acad. Bulg. Sci. 2020, 73, 220–226. [Google Scholar]
- Stoyancheva, G.; Dishliyska, V.; Miteva-Staleva, J.; Kostadinova, N.; Abrashev, R.; Angelova, M.; Krumova, E. Sequencing and gene expression analysis of catalase genes in Antarctic fungal strain Penicillium griseofulvum P29. Polar Biol. 2022, 45, 437–447. [Google Scholar] [CrossRef]
- Dishliyska, V.; Stoyancheva, G.; Abrashev, R.; Miteva-Staleva, J.; Spasova, B.; Angelova, M.; Krumova, E. Catalase from the Antarctic Fungus Aspergillus fumigatus I-9–Biosynthesis and Gene Characterization. Indian J. Microbiol. 2023, 63, 541–548. [Google Scholar] [CrossRef]
- Belozerskaya, T.; Aslanidi, K.; Ivanova, A.; Gessler, N.; Egorova, A.; Karpenko, Y.; Olishevskaya, S. Characteristics of extremophylic fungi from chernobyl nuclear power plant. Curr. Res. Technol. Educ. Top. Appl. Microbiol. Microb. Biotechnol. 2010, 1, 88–94. [Google Scholar]
- Miteva-Staleva, J.; Stefanova, T.; Krumova, E.; Angelova, M. Growth-phase-related changes in reactive oxygen species generation as a cold stress response in antarctic Penicillium strains. Biotechnol. Biotechnol. Equip. 2011, 25, 58–63. [Google Scholar] [CrossRef]
- Fridovich, I. Superoxide radical and superoxide dismutases. Annu. Rev. Biochem. 1995, 64, 97–112. [Google Scholar] [CrossRef]
- Harris, E.D. Regulation of antioxidant enzymes. FASEB J. 1992, 6, 2675–2683. [Google Scholar] [CrossRef] [PubMed]
- Rogalski, J.; Fiedurek, J.; Gromada, A. Purification of extracellular catalase from Aspergillus niger. Pol. J. Microbiol. 1998, 47, 31–43. [Google Scholar]
- Adeoyo, O.R.; Pletschke, B.I.; Dames, J.F. Purification and characterization of an amyloglucosidase from an ericoid mycorrhizal fungus (Leohumicola incrustata). AMB Express 2018, 8, 154. [Google Scholar] [CrossRef]
- Sun, S.; Zhang, Y.; Que, Y.; Liu, B.; Hu, K.; Xu, L. Purification and characterization of fungal laccase from Mycena purpureofusca. Chiang Mai J. Sci. 2013, 40, 151–160. [Google Scholar]
- Spiro, M.C.; Griffith, W.P. The mechanism of hydrogen peroxide bleaching. Text. Chem. Color. 1997, 29, 12–13. [Google Scholar]
- Margesin, R.; Schinner, F. Biological decontamination of oil spills in cold environments. J. Chem. Technol. Biotechnol. 1999, 74, 381–389. [Google Scholar] [CrossRef]









| N | Strain | Extracell. CAT (U/mg) | Intracell. CAT (U/mg) | N | Strain | Extracell. CAT (U/mg) | Intracell. CAT (U/mg) | N | Strain | Extracell. CAT (U/mg) | Intracell. CAT (U/mg) |
|---|---|---|---|---|---|---|---|---|---|---|---|
| 1. | P27 | 2.5 | 22.9 | 22. | I 9 | 3.09 | 5.72 | 43. | I 13 | 4.25 | 8.7 |
| 2. | P22 | 3.6 | 16.5 | 23. | III 21 | 3.20 | 8.16 | 44. | I 112 | 2.27 | 4.7 |
| 3. | III 63 | 2.3 | 14.7 | 24. | III 71 | 1.33 | 19.54 | 45. | I 111 | 3.5 | 33.9 |
| 4. | P21 | 0.6 | 11.3 | 25. | III 81 | 6.96 | 31.04 | 46. | I 141 | 7.3 | 15.4 |
| 5. | P29 | 3.9 | 28.9 | 26. | III 83 | 1.70 | 26.72 | 47. | 1 11 | 1.7 | 6.8 |
| 6. | M12 | 0 | 16.4 | 27. | I 141 | 3.76 | 4.89 | 48. | I BH | 1.6 | 15.0 |
| 7. | P44 | 1.5 | 9.4 | 28. | III 22 | 0 | 6.32 | 49. | I 15 | 2.2 | 31.1 |
| 8. | P31 | 0 | 35.7 | 29. | III 63 | 10.27 | 19.97 | 50. | I 82 | 2.7 | 33.2 |
| 9. | P33 | trace | 5.9 | 30. | III 221 | 0 | trace | 51. | I 9 | 3.9 | 39.2 |
| 10. | M5 | 0.9 | 10.4 | 31. | III 67 | 2.04 | 17.55 | 52. | I 8 | 0.8 | 18.9 |
| 11. | II 62 | 2.3 | 10.0 | 32. | II 51 | 1.42 | 12.39 | 53. | II 43 | 1.81 | 17.23 |
| 12. | II 65 | 3.0 | 15.3 | 33. | III 112 | 8.19 | 40.21 | 54. | I 73 | 1.77 | 4.38 |
| 13. | II 66 | 1.1 | 14.9 | 34. | K1 | 2.36 | 1.61 | 55. | I 16 | 3.5 | 33.1 |
| 14. | II 51 | 1.9 | 12.2 | 35. | K7 | 1.79 | trace | 56. | I 10 | 1.6 | 21.0 |
| 15. | T35 | 1.6 | 15.8 | 36. | I 141 | 3 | 5.52 | 57. | I 19 | 1.3 | 22.0 |
| 16. | 119 | 1.3 | 13.4 | 37. | 15 | 1.93 | 19.97 | 58. | I 72 | 3.4 | 36.9 |
| 17. | I 13 | 3.74 | 6.8 | 38. | 16 | 0.86 | 23.94 | 59. | I 92 | 2.5 | 6.02 |
| 18. | I 21 | 0 | 9.5 | 39. | 19 | 1.34 | 9.75 | 60. | I 21 | 4.8 | 7.1 |
| 19. | I 16 | 3.3 | 5.7 | 40. | 22 | 0 | 10.18 | 61. | 1 71 | 2.7 | 27.4 |
| 20. | I 112 | 3.12 | 3.8 | 41. | I S | 2.43 | 5.29 | 62. | I 112 | 2.6 | 17.5 |
| 21. | I 101 | 0.89 | 11.9 | 42. | Б32 | 1.64 | 12.09 |
| № | Strain Abbreviation | Strain Name | Macroscopic Picture | Taxonomy | NCBI GenBank Database Accession Numbers |
|---|---|---|---|---|---|
| 1. | P29 | Penicillium griseofulvum |  | Class: Eurotiomycetes Order: Eurotiales Family: Trichocomaceae Genus: Penicillium | MT722118 |
| 2. | P22 | Penicillium sp. |  | Class: Eurotiomycetes Order: Eurotiales Family: Trichocomaceae Genus: Penicillium | MT730073 |
| 3. | I1-6 | Penicillium rubens |  | Class: Eurotiomycetes Order: Eurotiales Family: Trichocomaceae Genus: Penicillium | MT758185 |
| 4. | I9 | Aspergillus fumigatus |  | Class: Eurotiomycetes Order: Eurotiales Family: Aspergillaceae Genus: Aspergillus | MT758189 |
| 5. | I11-2 | Penicillium rubens |  | Class: Eurotiomycetes Order: Eurotiales Family: Trichocomaceae Genus: Penicillium | MT722143 |
| 6. | I13 | Penicillium commune |  | Class: Eurotiomycetes Order: Eurotiales Family: Trichocomaceae Genus: Penicillium | MT730061 |
| 7. | I14-1 | Pseudogymnoascus pannorum |  | Class: Leotiomycetes Order: Helotiales Family: Myxotrichaceae Genus: Geomyces | MT722119 |
| 8. | III2-1 | Epicoccum nigrum |  | Class: Dothideomycetes Order: Pleosporales Family: Didymellaceae Genus: Epicoccum | OR844311 |
| 9. | III6-3 | Aspergillus glaucus |  | Class: Eurotiomycetes Order: Eurotiales Family: Aspergillaceae Genus: Aspergillus | JN206683.1 |
| 10. | III8-1 | Penicillium commune | | Class: Eurotiomycetes Order: Eurotiales Family: Trichocomaceae Genus: Penicillium | MT722126 |
| 11. | III11-2 | Penicillium rubens | | Class: Eurotiomycetes Order: Eurotiales Family: Trichocomaceae Genus: Penicillium | OR844310 |
| Sample | Volume (mL) | Protein (mg) | Specific CAT Activity (U/mg) | Total CAT Activity (U) | Yield (%) | Degree of Purification (Fold) |
|---|---|---|---|---|---|---|
| Output | 315 | 1.466 | 5.22 | 2410.50 | 100 | 1 |
| Ultrafiltration | 24 | 2.465 | 6.02 | 356.14 | 14.77 | 1.15 |
| (NH4)2SO4 Saturation | 20 | 1.528 | 18.31 | 559.55 | 23.21 | 3.51 |
| Column Q-Sepharose | 7.5 | 0.125 | 513.72 | 481.60 | 19.97 | 98.4 |
Disclaimer/Publisher’s Note: The statements, opinions and data contained in all publications are solely those of the individual author(s) and contributor(s) and not of MDPI and/or the editor(s). MDPI and/or the editor(s) disclaim responsibility for any injury to people or property resulting from any ideas, methods, instructions or products referred to in the content. |
© 2024 by the authors. Licensee MDPI, Basel, Switzerland. This article is an open access article distributed under the terms and conditions of the Creative Commons Attribution (CC BY) license (https://creativecommons.org/licenses/by/4.0/).
Share and Cite
Koleva, Z.; Abrashev, R.; Angelova, M.; Stoyancheva, G.; Spassova, B.; Yovchevska, L.; Dishliyska, V.; Miteva-Staleva, J.; Krumova, E. A Novel Extracellular Catalase Produced by the Antarctic Filamentous Fungus Penicillium Rubens III11-2. Fermentation 2024, 10, 58. https://doi.org/10.3390/fermentation10010058
Koleva Z, Abrashev R, Angelova M, Stoyancheva G, Spassova B, Yovchevska L, Dishliyska V, Miteva-Staleva J, Krumova E. A Novel Extracellular Catalase Produced by the Antarctic Filamentous Fungus Penicillium Rubens III11-2. Fermentation. 2024; 10(1):58. https://doi.org/10.3390/fermentation10010058
Chicago/Turabian StyleKoleva, Zdravka, Radoslav Abrashev, Maria Angelova, Galina Stoyancheva, Boryana Spassova, Lyudmila Yovchevska, Vladislava Dishliyska, Jeny Miteva-Staleva, and Ekaterina Krumova. 2024. "A Novel Extracellular Catalase Produced by the Antarctic Filamentous Fungus Penicillium Rubens III11-2" Fermentation 10, no. 1: 58. https://doi.org/10.3390/fermentation10010058
APA StyleKoleva, Z., Abrashev, R., Angelova, M., Stoyancheva, G., Spassova, B., Yovchevska, L., Dishliyska, V., Miteva-Staleva, J., & Krumova, E. (2024). A Novel Extracellular Catalase Produced by the Antarctic Filamentous Fungus Penicillium Rubens III11-2. Fermentation, 10(1), 58. https://doi.org/10.3390/fermentation10010058





